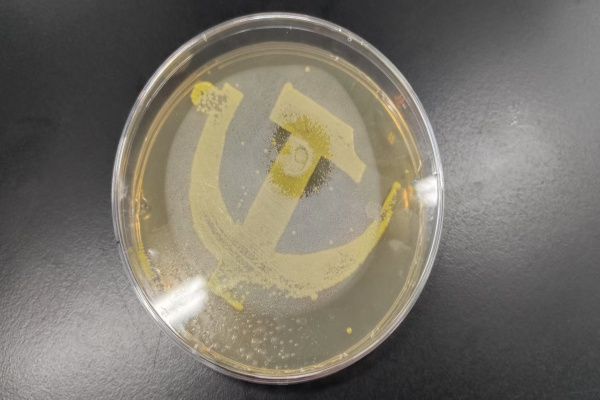

7月15日,一场别开生面的科学训练营在理科楼微生物实验室成功举办。过程中,林雁冰老师以丰富的知识和生动的案例,带同学们走进了微生物的奇妙世界。
林老师首先为大家简单介绍了微生物的定义、种类和发展历程,同学们清晰了解这门学科的发展脉络。随后,重点阐述了微生物在人类生活中的多样作用:食品领域、健康领域、工业、农业和环境保护中都有它的身影。同时,林老师也提醒同学们注意微生物对健康的危害,特别强调了米酵菌酸的危害及预防措施,让同学们提高防范意识。

讲座结束后,同学们兴致勃勃地参与了微生物作画活动。在老师的指导下,大家利用不同种类微生物的生长特性和颜色差异,在培养基上构思、创作。活动现场热闹非凡,同学们充分发挥想象力,有人表达红色情怀,有人展现国宝风姿,有人充满童趣色彩,每一幅作品都独一无二,是微生物与艺术的完美结合。
此次活动不仅让同学们系统学习了微生物知识,更能亲手实践,感受微观世界的神奇与美妙,加深了对微生物的理解和兴趣。正如林雁冰老师所说,人类与微生物时刻"共舞",了解它们、利用它们,才能更好地与这些微小的"朋友"和谐共处。

